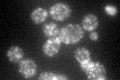
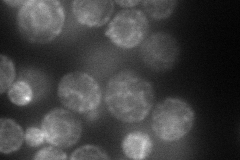
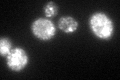
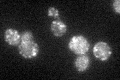

View description
Component of the Sec23p-Sfb3p heterodimer of the COPII vesicle coat, required for cargo selection during vesicle formation in ER to Golgi transport; homologous to Sec24p and Sfb2p
Localization:
Intensity:
Fold change:
Significance:
-
C’ GFP library in SD
punctate62.22 -
N' NOP1pr-GFP in SD
cell periphery,ER,punctate92.956 -
N' TEF2pr-mCherry in SD

ER,punctate,vacuole49.5268 -
N' NATIVEpr-GFP in SD

cell periphery,ER,punctate61.9138 -
N' TEF2pr-VC and Cyto-VN in SD

#N/A0 -
C’ GFP library in SD+DTT
punctate64.081.02No -
C’ GFP library in SD+H2O2

punctate60.380.97No -
C’ GFP library in Starvation Media
punctate53.730.86No -
C’ GFP library on the background of Pup2-DaMP

punctate -
C’ GFP library on the background of CCT mutant

punctate58.10490.933779No
